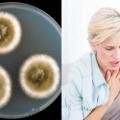
mouhla.jpg

Ορισμένα καρδιακά επεισόδια «χτυπούν» ξαφνικά, αλλά πολλοί έχουν προειδοποιητικά σημάδια και συμπτώματα ώρες, ημέρες, ή και εβδομάδες νωρίτερα.
Υπάρχουν σημάδια που, αν τα δείτε, καλύτερα να φύγετε από τη σχέση ή τον γάμο σας τρέχοντας πριν να είναι αργά...
Τι αποκάλυψε η ηθοποιός;
Συγκινεί με την ανάρτησή της
Mε μεγάλη συμμετοχή βρεφονηπιοκόμων και νηπιαγωγών από το νομό Ηρακλείου, πραγματοποιήθηκε σήμερα, στην αίθουσα...
Ο Τάκης Ζαχαράτος στην τελευταία του ανάρτηση στο instagram μοιράστηκε το πρόβλημα που αντιμετωπίζει με τ
Ερευνητές από το πανεπιστήμιο του Yale στις ΗΠΑ διαπίστωσαν ότι η σχιζοφρένεια...
Μήπως έχετε μούχλα στο σπίτι σας; Εάν ναι, θα πρέπει να γνωρίζετε...
Τα εγκεφαλικά επεισόδια (ΑΕΕ) αποτελούν την τρίτη αιτία θανάτου στον δυτικό κόσμο...
Αν έχεις ουλές ή σημάδια στο πρόσωπο σου που έχουν προκληθεί από ακμή ή άλλες αιτίες τότε έχεις μια οικονομική και εύκολη λύση με υλικά που έχεις στην κουζίνα σου..
Εάν έχετε οποιαδήποτε από αυτές τις παρακάτω παρενέργειες θα μπορούσε να σημαίνει ότι έχετε δυσανεξία...